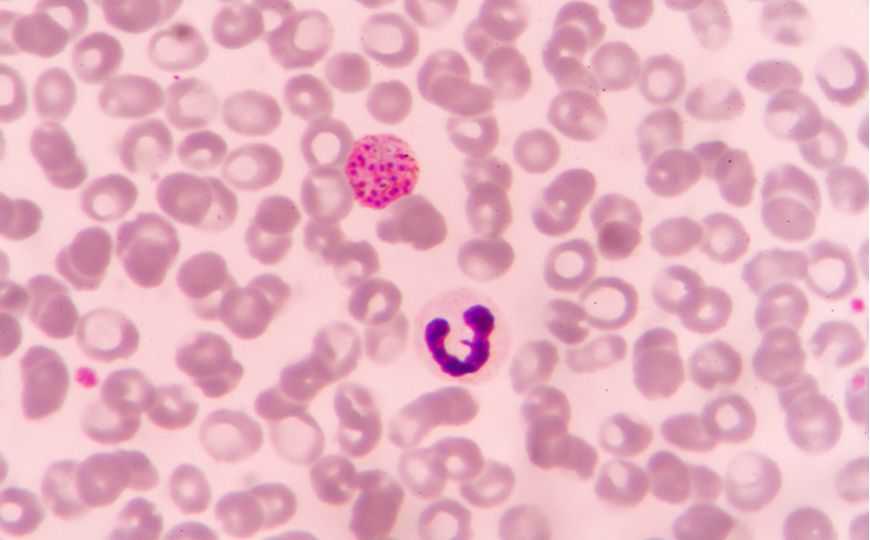

Пантотенамиды — новый класс противомалярийных препаратов
Некоторые производные пантотеновой кислоты — пантотенамиды подавляют размножение малярийного паразита в крови и предотвращает распространение инфекции комарами. Механизм действия этих веществ уникален для противомалярийных препаратов, и это делает их эффективными против патогенов, обладающих множественной лекарственной устойчивостью к существующим средствам.
Малярийный плазмодий в эритроцитах крови. Credit: plenoy m | Shutterstock.com
По данным Всемирной организации здравоохранения от малярии ежегодно умирают более 400 000 человек. В последние годы темпы снижения числа случаев заболевания и летальных исходов замедляются. Борьба с инфекцией направлена как на возбудителей малярии — одноклеточных паразитов рода Plasmodium, так и на комаров рода Anopheles, распространяющих патоген через укусы.
Эффективность пантотенамидов в отношении малярийного плазмодия давно была продемонстрирована в экспериментах in vitro. Однако их не удавалось применить для лечения инфекции, поскольку в организме данные соединения подвергаются ферментативному расщеплению. Авторы исследования, опубликованного в Science Translational Medicine, получили ряд стабильных веществ, которые могут применяться в качестве противомалярийных препаратов. Четыре из них были эффективны в наномолярных концентрациях.
Эффективность усовершенствованных пантотенамидов проверили на гуманизированных мышах, зараженных Plasmodium falciparum, который вызывает наиболее тяжелую форму малярии. Исследование показало, что соединения действуют как на бесполую, так и на половую стадии жизненного цикла паразита, подавляя его развитие в крови млекопитающего и в кишечнике комара.
Пантотенамиды обладают химической структурой, схожей с пантотеновой кислотой, или витамином B5 — важным питательным веществом для плазмодия. Как показал анализ метаболома, пантотенамиды метаболизируются его клетками по тому же пути, что витамин В5. Возникающие при этом продукты подавляют синтез ацетилкофермента А, необходимого для выживания паразита. Исследование геномов устойчивых форм P. falciparum, полученных воздействием больших доз препаратов, а также CRISPR-Cas-редактирование генов ацетилКоА-синтетазы и ацил-коА-синтетазы 11 в геноме плазмодия подтвердили, что за чувствительность к пантотенамидам отвечают именно эти ферменты. Препараты с подобным механизмом действия ранее не применялись для лечения малярии.
«Пантотенамиды представляют собой простые соединения, поэтому их легко и недорого производить, — говорит Мануэль Линас из Пенсильванского университета (США), один из авторов работы. — Теперь мы знаем механизм их действия, который далеко не всегда бывает известен перед началом разработки препаратов. Это делает пантотенамиды отличными кандидатами для дальнейшего улучшения и в конечном счете для клинических испытаний».
Источники
Joost Schalkwijk, et. al. // Antimalarial pantothenamide metabolites target acetyl–coenzyme A biosynthesis in Plasmodium falciparum. // Science Translational Medicine, 2019; DOI: 10.1126/scitranslmed.aas9917
Статья на BioRxiv
Цитата по пресс-релизу


 Меню
Меню





 Все темы
Все темы




 0
0












